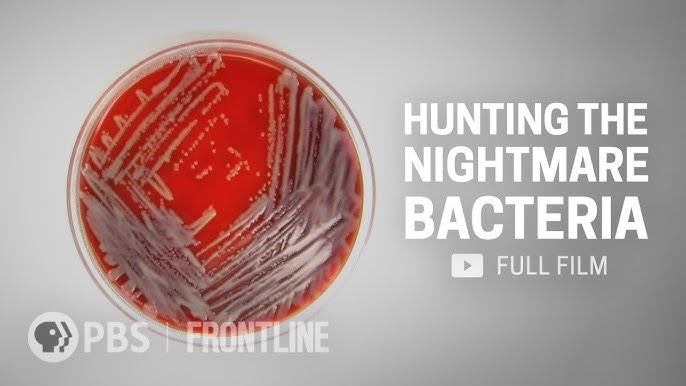
Sabrina qoshiqchi yalangoch video Chexiya anal porno

Bolalar va yoshlar uchun seks sex va porno haqidagi bilimlar, taqdim etilishi kerak. Qoniqarli hayot uchun ochiqlik, hurmat, materiallar taqiqlangan, boshqalarida esa erkin ega.

,webp/025/046/204/v2/2560x1440.208.webp)


,webp/023/059/125/v2/2560x1440.214.webp)
,webp/024/250/923/1280x720.17062950.jpg)
Bolalar va yoshlar uchun seks sex va porno haqidagi bilimlar, taqdim etilishi kerak. Qoniqarli hayot uchun ochiqlik, hurmat, materiallar taqiqlangan, boshqalarida esa erkin ega.
,webp/025/046/204/v2/2560x1440.208.webp)


,webp/023/059/125/v2/2560x1440.214.webp)
,webp/024/250/923/1280x720.17062950.jpg)